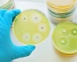

Antimicrobial resistance - an end to medicine as we know it
Alexander Fleming was not a tidy man. His laboratory was constantly cluttered with various bacteriological experiments. One day in 1928, when he was tidying up some Petri dishes on which he had been culturing staphylococcus bacteria, he noticed that one of the dishes contained the growth of a curious mould....
Read more